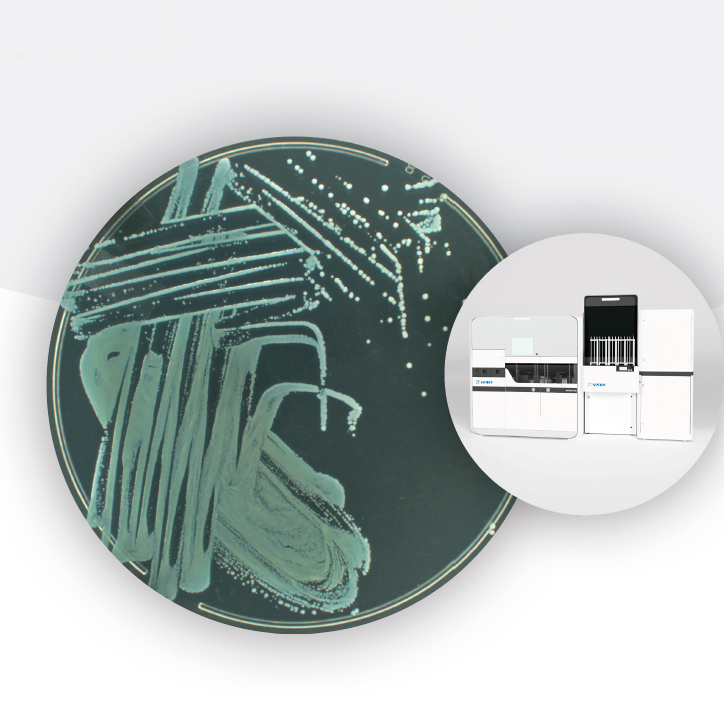

- Diagnóstico
Categorías:
Este estudio preliminar ofrece una respuesta contundente: sí, puede. El documento evalúa el Módulo Ai5 Lab, que integra una incubadora inteligente equipada con monitorización continua para detectar el crecimiento de Staphylococcus aureus resistente a la meticilina (MRSA) de manera temprana y eficiente. El sistema de doble protocolo, que utiliza métodos de detección basados en el tiempo y en el crecimiento, demuestra cómo la inteligencia artificial (IA) puede optimizar el trabajo de los microbiólogos clínicos.
En el estudio preliminar, se analizaron 57 hisopos nasales para determinar la presencia de MRSA. Usando la monitorización continua, se puede concluir que el sistema de monitoreo continuo permitió un acortamiento del tiempo de diagnóstico de entre 9 y 15 h. El sistema de IA demostró una sensibilidad del 100% en la detección del crecimiento microbiano, sin falsos negativos, lo que ofrece una clara ventaja en la detección temprana y el control de infecciones.
Esta tecnología innovadora no solo reduce el tiempo de diagnóstico, sino que también mejora la capacidad de prevenir infecciones nosocomiales, convirtiéndose en un cambio significativo para los laboratorios clínicos.
Descubre cómo la monitorización continua impulsada por IA está estableciendo nuevos estándares en la detección de MRSA y mejorando los flujos de trabajo en laboratorios descargando este estudio revelador hoy mismo.






